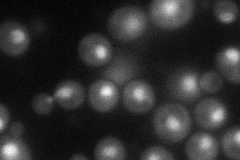
YPL181W
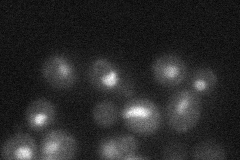
YPL181W
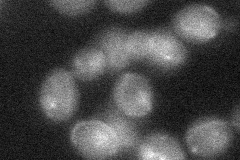
YPL181W
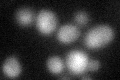
YPL181W

View description
Protein that relieves transcriptional repression by binding to the Cyc8p-Tup1p corepressor and recruiting the SAGA complex to the repressed promoter; contains a PHD finger domain
Localization:
Intensity:
Fold change:
Significance:
-
C’ GFP library in SD

below threshold15.97 -
N' NOP1pr-GFP in SD
nucleolus55.5658 -
N' TEF2pr-mCherry in SD

nucleus12.8631 -
N' NATIVEpr-GFP in SD
nucleus30.5147 -
N' TEF2pr-VC and Cyto-VN in SD
nucleus27.5157 -
C’ GFP library in SD+DTT
cytosol18.651.16No -
C’ GFP library in SD+H2O2

cytosol16.461.03No -
C’ GFP library in Starvation Media

cytosol15.820.99No -
C’ GFP library on the background of Pup2-DaMP

below threshold -
C’ GFP library on the background of CCT mutant

below threshold16.22381.01549No
